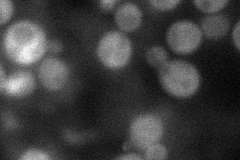
YOR353C
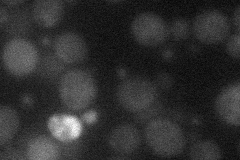
YOR353C
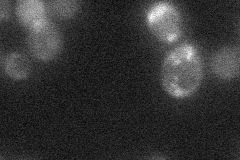
YOR353C
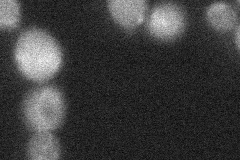
YOR353C

View description
Key component of the RAM signaling network, required for proper cell morphogenesis and cell separation after mitosis
Localization:
Intensity:
Fold change:
Significance:
-
C’ GFP library in SD

cytosol25.16 -
N' NOP1pr-GFP in SD
cytosol38.9489 -
N' TEF2pr-mCherry in SD
cytosol15.9414 -
N' NATIVEpr-GFP in SD
cytosol23.3731 -
N' TEF2pr-VC and Cyto-VN in SD
below threshold27.5097 -
C’ GFP library in SD+DTT

cytosol26.561.05No -
C’ GFP library in SD+H2O2

cytosol27.131.07No -
C’ GFP library in Starvation Media

cytosol24.310.96No -
C’ GFP library on the background of Pup2-DaMP

cytosol -
C’ GFP library on the background of CCT mutant

cytosol28.53731.13383No
